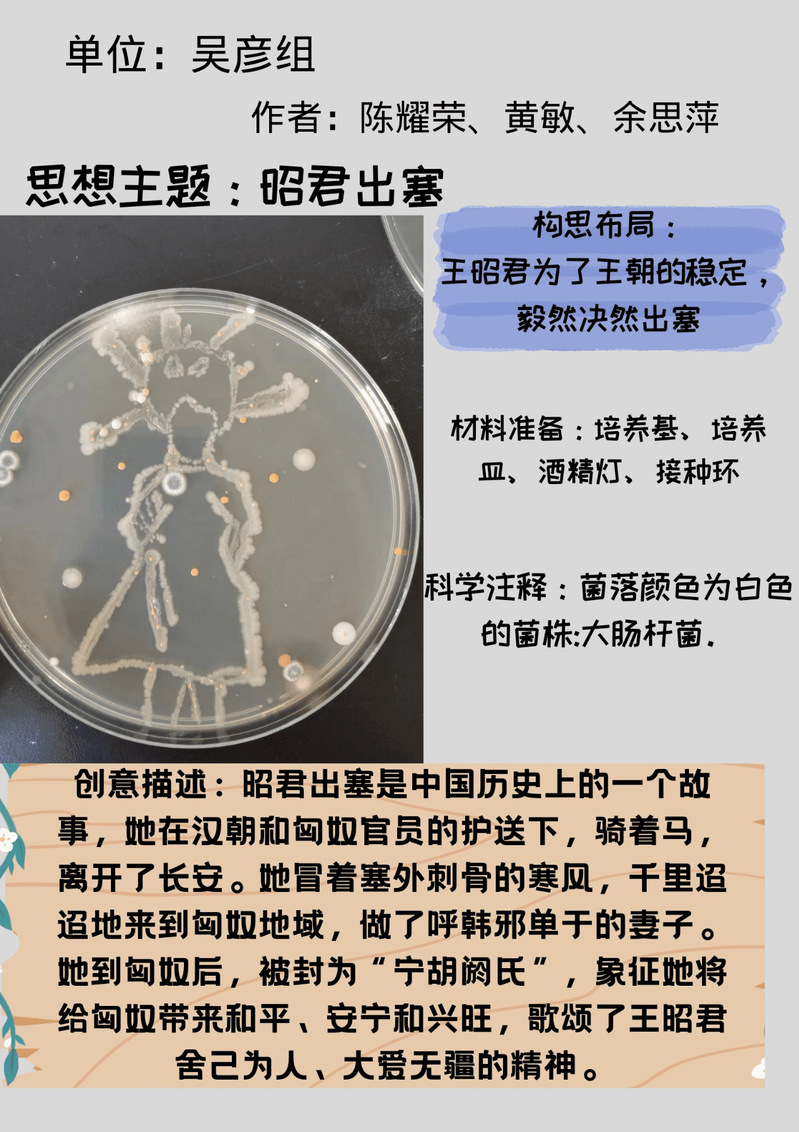

为向广大师生生动展示微生物世界的魅力,强化学生对专业知识的理解,广西师范大学生命科学学院团委历时2个月成功举办“妙菌生画·迎独秀九秩”为主题的培养皿设计大赛。
学院陆祖军教授从创作灵感、制作材料、制作过程、作品拍摄、海报制作、内涵挖掘等方面为参赛团队进行赛前培训。参赛团队在培养皿的方寸之地,用微生物构成的线条、画面展现在小小的培养皿中,有充满力量的拳头、有优秀榜样的形象、有美丽校园环境,各团队用小小的微生物展示了他们对红色精神的理解、对英雄榜样的敬意、对祖国对学校的无限热爱。
本次比赛是一场科学和艺术的“相逢”,充分展示了学院学生的专业素养,也生动展现出生物学科的独特魅力。未来,学院将持续开展创新性第二课堂活动,为师生抒发对祖国、对学校的热爱提供良好的平台,引导青年学生在实践中探索新思路、展现新作为,以优异成绩迎接党的二十大胜利召开,庆祝建校90周年。
(文/钱丽羽 图/生命科学学院 审/秦乐)


陆祖军教授为同学们做赛前培训

各个参赛小组作品展示
桂公网安备45030502000260号)